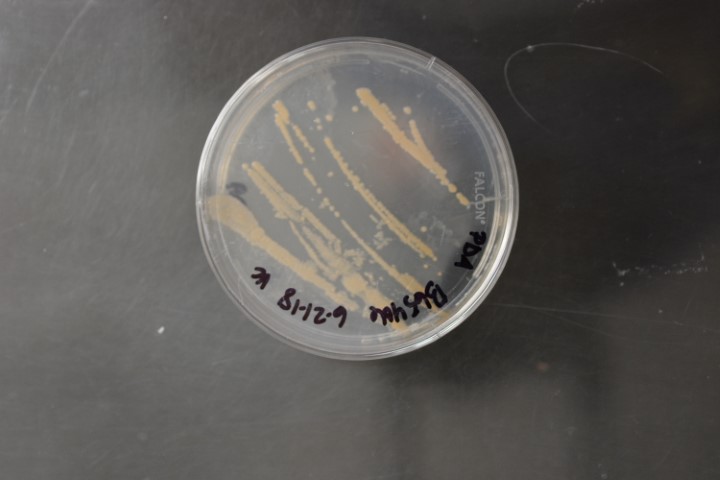

Rhodococcus gingshengii
NRRL B-65406
Accession numbers in other collections:CW25
Source:Jean-Francois Pombert;Illinois Institute of Technology
Isolated from(substrate):soil
Substrate location:unknown,unknown
Growth media:Potato Dextrose Agar(number 3)
Optimum growth temperature:30C
Strain images:
NRRL_B-65406_3.JPG